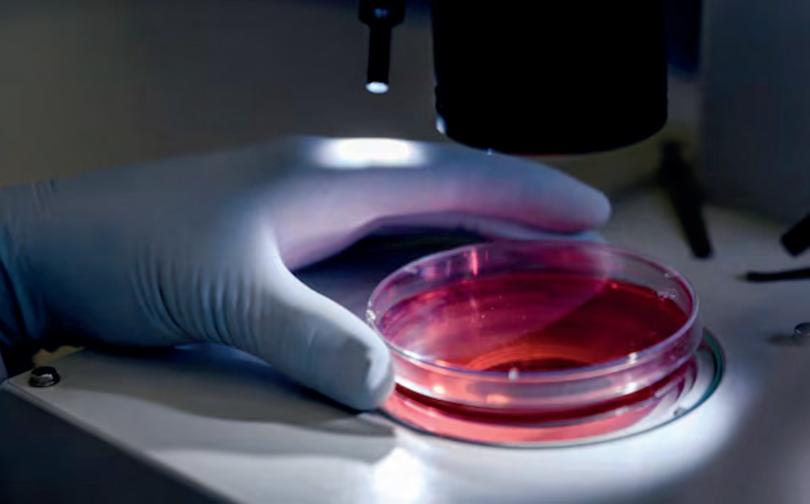

Incendio en vivienda de Quillota dejó cinco damnificados

Una segunda casa resultó con daños por radiación y humo
Adulto mayor recuperó $5 millones tras “cuento del tío” en Limache

Madre e hijos detenidos por brutal homicidio en Valparaíso

![]()

Una segunda casa resultó con daños por radiación y humo
Adulto mayor recuperó $5 millones tras “cuento del tío” en Limache

Madre e hijos detenidos por brutal homicidio en Valparaíso

Una segunda casa resultó con daños por radiación y humo
Cuando eran cerca de las 22 horas del martes 3 de marzo, se produjo un incendio estructural en una vivienda de la calle Diego Echeverría, a la altura del número 513, en la población Portales.
La Central de Alarmas del Cuerpo de Bomberos despachó varias unidades al lugar y los voluntarios bomberiles estuvieron trabajando arduamente para apagar las llamas. La empresa Chilquinta efectuó un corte de energía preventivo en varios sectores de la comuna, para resguardar la seguridad de los bomberos que estaban combatiendo el siniestro.
También acudieron a apoyar en el control de la emergencia voluntarios del Cuerpo de Bomberos de La Cruz, además de profesionales de la Oficina municipal de Gestión de Riesgo de Desastres de Quillota, una ambulancia de Samu Base SSVQ Quillota y funcionarios de Seguridad Pública municipal.
El fuego consumió por completo una vivienda en la Población Portales y afectó también a un segundo domicilio. En este último la principal área afectada son parte de los dormitorios, que se encuentran en la parte superior de la casa.
LAS PERSONAS DAMNIFICADAS SON DOS ADULTOS Y TRES MENORES DE EDAD
La encargada de turno de Gestión de Riesgo, Damary Paredes Núñez, informó que cinco personas resultaron damnificadas en este incendio.
“A raíz de la emergencia mantenemos una familia damnificada y una familia afectada en la segunda vivienda. La familia damnificada se compone por tres menores de edad y dos adultos, quienes se


trasladaron a una vivienda de familiares para poder pasar la noche”, detalló Damary Paredes Núñez.
“El día de hoy (miércoles) se realizarán las labores respectivas para coordinar la limpieza, el retiro de escombros, pero además se evaluarán los casos sociales respectivos a las familias afectadas por el incendio (…) Se le entregaron ayudas primarias a la familia damnificada, consistente en enseres básicos como colchones, frazadas, almohadas, a fin de que ellos pudiesen restablecerse durante esta y algunas otras noches en otro domicilio o en otro lugar, pero adicionalmente se evalúan las siguientes gestiones respecto de la situación propia de la familia”, indicó la profesional de Gestión de Riesgo de la Municipalidad de Quillota.
Las causas y el origen de este siniestro están siendo investigadas por el departamento técnico de Bomberos especializado en esta materia, con el apoyo de efectivos de Labocar.
CUATRO BOMBEROS RESULTARON HERIDOS TRAS SER MORDIDOS POR UN PERRO
Por su parte, el comandante del Cuerpo de Bomberos de Quillota, Marco Velásquez Godoy, informó: “Al arribo de las unidades se declara esta emergencia, que se encontraba en libre combustión con propagación a otras viviendas. Se afectó en un 100% la vivienda que se encontraba siniestrada y otra por radiación y por humo se afectó en un 10% aproximadamente. En el lugar se hizo presente la Primera, Segunda, Tercera y Cuarta compañía y el Cuerpo de Bomberos de la Cruz para combatir este incendio. Más de 40 bomberos trabajaron en el control de la emergencia“.
“Tuvimos cuatro bomberos lesionados producto de la mordedura de un can del mismo domicilio que estaba siendo afectado en el incendio, que fueron trasladados al SAR de Quillota para su atención. No hubo personas civiles lesionadas”, agregó el comandante Marco Velásquez.

La rápida acción de Seguridad Pública y Carabineros permitió detener a los responsables luego de un seguimiento en tiempo real a través de cámaras de vigilancia.
Un adulto mayor logró recuperar cinco millones de pesos luego de ser víctima de un intento de robo mediante engaño en el centro de Limache, hecho que terminó con los responsables detenidos gracias a la rápida coordinación entre Seguridad Pública y Carabineros. El episodio se registró luego de que la víctima realizara un retiro de dinero en una sucursal bancaria ubicada en calle Serrano. Posteriormente se trasladó en su vehículo hasta un café del centro de
la comuna, aparentemente sin percatarse de que estaba siendo seguido.
Tras retomar la marcha junto a familiares, el conductor comenzó a notar que una de las ruedas del automóvil presentaba problemas, aparentemente desinflándose de manera repentina. Ante esta situación decidió detenerse en la intersección de Carelmapu con Palmira Romano para revisar el vehículo.
En ese momento, un grupo de sujetos se acercó con la aparente intención de ayudar al conductor, iniciando una conversación para distraerlo. Aprovechando la situación, uno de los individuos ingresó al automóvil y sustrajo una mochila que contenía los cinco millones de pesos que el adulto mayor había retirado previamente desde el banco.
Sin embargo, la acción fue detectada por el sistema de cámaras de vigilancia comunal, lo que permitió realizar un se -
guimiento en tiempo real de los sospechosos. Esta información fue clave para que personal de Seguridad Pública que patrullaba el sector llegara rápidamente al lugar y alertara a Carabineros.
Gracias a esta coordinación, los sujetos fueron interceptados y detenidos en las inmediaciones, recuperándose además el dinero sustraído, el cual fue devuelto a su propietario.
El caso también volvió a poner en alerta sobre este tipo de delitos conocidos como “cuento del tío”, en los que los delincuentes provocan situaciones para distraer a las víctimas y sustraer especies de valor, especialmente tras giros de dinero en entidades bancarias.
Desde las autoridades reiteraron el llamado a mantener precaución al realizar este tipo de trámites y evitar trasladar grandes sumas de dinero sin medidas de seguridad o acompañamiento.

En mayo el sacerdote celebrará su cumpleaños número 95
El padre Pedro Aguiar Darrouy continúa con su proceso de recuperación en su hogar de la villa Empart de La Calera. En las últimas semanas el párroco ha presentado algunos problemas en su salud, por lo que ha tenido dos internacionales hospitalarias, en las que cuales se le han hecho exáme-
nes para determinar cuál es la enfermedad que lo pudiera estar afectando.
Como informó Observador.cl en enero pasado, el padre Pedro Aguiar fue internado en la Clínica de la Universidad Católica de Santiago, donde fue sometido a una serie de evaluaciones y tratamientos que le han permitido, en gran medida, recuperarse. Sin embargo, la semana pasada el sacerdote debió ser internado nuevamente, esta vez en la clínica de RedSalud en Valparaíso. Hace un par de días el padre recibió el alta médica y volvió a su hogar,
donde actualmente se encuentra dedicado a la oración y dando cuenta de su tradicional buen humor.
El padre Pedro señaló estar en una etapa de recuperación, en espera para cumplir sus 95 años en el próximo mes de mayo. Dijo que tiene su espíritu intacto para atender a la comunidad calerana y volver a celebrar las misas en la Parroquia Santo Nombre de Jesús, o también en la comunidad de religiosas de la Abadía Santa María de Rautén en Quillota, a quienes también sirve con su labor sacerdotal.
Actualmente, estos dispositivos superan los 15 años de funcionamiento y se encuentran fuera de la normativa vigente del Ministerio de Transportes y Telecomunicaciones
La Municipalidad de La Cruz, a través de su Secretaría Comunal de Planificación (SECPLAN) y la Dirección de Tránsito, se encuentra trabajando en un proyecto de modernización y normalización de los tres puntos de semaforización existentes en la comuna, iniciativa que se encuentra en postulación a financiamiento mediante la Subsecretaría de Desarrollo Regional y Administrativo (SUBDERE).
Los cruces contemplados corresponden a Calle 2 con Av. 21 de Mayo; Calle Calama con Av. 21 de Mayo; y Calle Simpson con Av. 21 de Mayo, intersecciones que concentran un alto flujo vehicular y peatonal.
Actualmente, estos dispositivos superan los 15 años de funcionamiento y se encuentran fuera de la normativa vigente del Ministerio de Transportes y Telecomunicaciones, presentando un importante nivel de deterioro y diversas fallas mecánicas, eléctricas y estéticas que afectan su correcto desempeño y la seguridad vial del sector.

El director de Tránsito, David Leyton, explicó que “estamos preparando con el equipo de SECPLAN una postulación de reacondicionamiento de proyectos de semaforización, de modernización y normalización de los cruces antiguos que tiene la comuna de La Cruz”, destacando que se trata de dispositivos con más de 15 años de antigüedad y que ya no cumplen con la normativa actual.
En ese sentido, detalló que por solicitud de la alcaldesa y la gestión municipal se está avanzando en la postulación a fondos SUBDERE, con el objetivo de concretar una mejora sustantiva en la infraestructura. El proyecto contempla la instalación de nuevos controladores, sistemas UPS, nuevas programaciones y equipamiento completamente renovado, cuya implementación deberá ser aprobada por la Unidad Operativa de Control de Tránsito (UOCT), organismo encargado
de regular este tipo de instalaciones.
Asimismo, se consideran obras civiles subterráneas con cámaras especiales, eliminando el cableado aéreo y reduciendo la contaminación visual en el entorno urbano.
Leyton subrayó que esta modernización permitirá disminuir riesgos asociados a cortes de energía o fallas por fatiga de material, situaciones que actualmente pueden generar interrupciones en el servicio. “Más de 15 años es una fecha prudente de uso de estos dispositivos, por eso se hace necesaria su actualización, con la finalidad de evitar accidentes de tránsito en la comuna de La Cruz”, enfatizó.
Con esta iniciativa, el municipio busca fortalecer la seguridad vial tanto para peatones como para conductores, promoviendo desplazamientos más seguros y eficientes en puntos estratégicos de la comuna.

La core por la provincia de San Felipe, Maricel
Martínez, destacó que el proyecto ferroviario podría mejorar la movilidad en el valle y facilitar el traslado de pacientes hacia centros de atención en Valparaíso
El eventual retorno del tren de pasajeros al Valle de Aconcagua comienza a generar expectativas en el territorio. La consejera regional por la provincia de San Felipe, Maricel Martínez, manifestó su respaldo al proyecto ferroviario que evalúa la Empresa de Ferrocarriles del Estado (EFE), iniciativa que actualmente se encuentra en etapa de análisis técnico tras la presentación de los resultados preliminares del estudio de factibilidad.
Según explicó la autoridad, el estudio fue financiado con recursos del Gobierno Regional y ya fue presentado al gobernador Rodrigo Mundaca, mientras que en los próximos días EFE expondrá sus principales conclusiones ante el Consejo Regional de Valparaíso.
“El rol del Consejo Regional ha sido financiar los estudios de factibilidad y eventualmente apoyar algunas inversiones específicas que requiera la empresa. Financiar completamente un proyecto de esta magnitud es imposible para el Gobierno Regional por el alto costo que implica”, explicó la consejera.
Martínez señaló que en el Valle de Aconcagua existe una fuerte memoria histórica vinculada al tren, que durante gran parte del siglo pasado fue uno de los principales medios de transporte entre las comunas del territorio.
La consejera recordó que hasta la década de los noventa el tren seguía siendo utilizado por los habitantes del valle, especialmente por estudiantes y trabajadores que se movilizaban entre distintas ciudades.
“Hay una añoranza importante por

el tren. Hasta los años noventa funcionaba y muchos estudiantes viajaban los domingos a tomarlo en la estación. Era un medio de transporte seguro, con horarios claros de salida y llegada”, relató.
En ese sentido, aseguró que recuperar el servicio ferroviario permitiría mejorar la movilidad interna del valle, especialmente entre comunas como San Felipe, Los Andes y Catemu, donde existe un alto flujo diario de trabajadores.
“Tenemos muchas personas que se trasladan todos los días entre distintas comunas del valle por trabajo. Contar con un sistema de transporte ferroviario para trayectos más cortos dentro del Aconcagua sería muy importante para la movilidad de sus habitantes”, afirmó.
IMPACTO EN SALUD Y CONECTIVIDAD REGIONAL
La autoridad también planteó que el retorno del tren podría tener un impacto significativo en el acceso a servicios de salud especializados, especialmente para pacientes que deben trasladarse desde el valle hacia hospitales o clínicas de Valparaíso y Viña del Mar.
Martínez explicó que actualmente muchos pacientes dependen de buses o vehículos particulares para asistir a controles o tratamientos, lo que puede verse afectado por congestión o accidentes en las carreteras.
“Tenemos pacientes oncológicos que deben viajar a Valparaíso o Viña del Mar para sus tratamientos. Muchas veces pierden sus horas médicas por accidentes o congestión en la carretera. Con el tren podríamos tener horarios claros de llegada y salida, lo que ayudaría mucho
a quienes necesitan trasladarse por temas de salud”, señaló.
LAS DUDAS QUE DEBERÁ RESOLVER EL ESTUDIO
En los próximos días, el Consejo Regional recibirá una exposición de EFE donde se abordarán en detalle las conclusiones del estudio de factibilidad. La consejera adelantó que existen varias interrogantes que deberán aclararse antes de avanzar hacia una etapa de ejecución.
Entre ellas mencionó el costo del proyecto, el valor que tendría el pasaje, los tiempos de traslado entre ciudades y las estaciones que podrían ser habilitadas o recuperadas en el valle.
“Hay estaciones que hoy están abandonadas, por lo tanto es importante saber cuáles se van a recuperar primero, cuánto costará mejorar las vías y cuánto tiempo tomaría habilitar el servicio para pasajeros”, explicó.
Otro de los aspectos clave será definir si el sistema combinará transporte de pasajeros con carga y cuáles serían los tiempos de desplazamiento entre el Valle de Aconcagua y el Gran Valparaíso.
Aunque el proyecto aún se encuentra en etapa de estudio, la consejera reconoció que en el valle existe una mezcla de esperanza y cautela, especialmente considerando los largos procesos que han tenido otras iniciativas ferroviarias en la región.
“Esperamos que este proyecto avance y no se demore tanto como otras iniciativas. Hay mucha expectativa en el Valle de Aconcagua por volver a tener el tren”, concluyó.


Una manipuladora de alimentos fue trasladada al Hospital de La Ligua tras presentar algunos síntomas compatibles con una posible intoxicación
Una emanación de gas desde la cocina del Liceo Pulmahue obligó a activar un operativo preventivo en el establecimiento. Todo ocurrió mientras se desarrollaba el primer día de clases del colegio, en la mañana de este miércoles 4 de marzo.
Mientras se tomaban medidas para resguardar a la comunidad educativo, se hizo un llamado de ayuda a los bomberos de La Ligua, quienes acudieron al lugar y trabajaron en controlar la emergencia sin mayores inconvenientes.
El Servicio Local de Educación Pública (SLEP) Petorca informó que no hubo estudiantes, docentes o funcionarios afectados, aunque una manipuladora de alimentos sufrió algunos síntomas que se habrían debido a la exposición al gas. La trabajadora fue derivada al Hospital San Agustín de La Ligua para ser evaluada. Una vez que se dio por superada la emergencia, el establecimiento continuó con sus actividades de manera normal.


Una mujer y sus tres hijos —dos de ellos menores de edad— fueron capturados por la PDI por su presunta participación en el crimen ocurrido el 28 de febrero en calle Uruguay
Un homicidio ocurrido en pleno centro de Valparaíso terminó con la detención de un clan familiar acusado de participar en el violento ataque que le costó la vida a un hombre de 33 años.
Detectives de la Brigada de Homicidios de la Policía de Investigaciones (PDI) de Valparaíso, en coordinación con el Ministerio Público, concretaron la captura de una mujer chilena de 43 años y de sus tres hijos, uno de ellos mayor de edad y dos adolescentes de 15 años, quienes estarían directamente vinculados con el crimen registrado el pasado 28 de febrero en calle Uruguay, entre Independencia y Victoria.
De acuerdo con los antecedentes reunidos durante la investigación, la víctima transitaba por el sector cuando fue interceptada por al menos tres individuos, quienes lo atacaron con armas cortantes en medio de una agresión que terminó siendo fatal.
Tras el llamado de emergencia, personal especializado de la Brigada de Homicidios y peritos del Laboratorio de Criminalística Regional se trasladaron al sitio del suceso para iniciar las primeras diligencias. El examen realizado por el médico criminalista estableció que el hombre presentaba múltiples heridas cortantes y cortopenetrantes en las extremidades superiores, además de lesiones torácicas y abdominales, todas provocadas con arma blanca y que finalmente le causaron la muerte.
El trabajo investigativo en el lugar del crimen, sumado al análisis criminal, levantamiento de evidencias y diligencias de inteligencia policial, permitió a los detectives reconstruir la dinámica del ataque y posicionar a los presuntos responsables.
El jefe de la Brigada de Homicidios Valparaíso, subprefecto Rodrigo Gallardo, explicó los hechos. “la Brigada de Homicidios, junto a su equipo especializado, logró la detención de un clan familiar compuesto por una mujer chilena de 43 años y sus tres hijos, uno mayor de edad y dos adolescentes de 15 años, por su responsabilidad en el delito de homicidio con arma cortante ocurrido el pasado 28 de febrero en calle Uruguay”, señaló.
El oficial agregó que las aprehensiones fueron posibles gracias al trabajo investigativo desarrollado por la policía civil en coordinación con la Fiscalía Local de Valparaíso, luego de reunir diversos elementos probatorios que permitieron tramitar las órdenes de detención respectivas.
Con las órdenes judiciales en mano, los detectives concretaron la captura de los cuatro imputados durante la jornada de ayer. Todos fueron puestos a disposición del Juzgado de Garantía para su control de detención y posterior formalización por el delito de homicidio.


El Delegado
Presidencial
Regional, Yanino Riquelme, destacó que la ampliación portuaria en Valparaíso podría generar miles de puestos de trabajo y fortalecer el rol estratégico del principal puerto regional
Más de 2.500 puestos de trabajo podrían generarse en la Región de Valparaíso tras la aprobación unánime del proyecto de ampliación portuaria
TCVAL por parte de la Comisión de Evaluación Ambiental Regional la jornada de este martes 3 de marzo.
El Delegado Presidencial Regional, Yanino Riquelme, calificó la jornada como “un día relevante”, subrayando que la iniciativa no solo fortalece la infraestructura marítima, sino que abre una expectativa concreta de empleo para la zona. Los puestos proyectados consideran trabajo directo, indirecto e inducido, vinculados tanto a la construcción como a la futura operación del terminal.
E l proyecto, presentado por la Empresa Portuaria de Valparaíso, permitirá recibir naves de mayor calado y envergadura, en un contexto donde más del 90%
de la carga del país se transporta por vía marítima. Para la autoridad regional, la ampliación es clave para sostener la competitividad del puerto y asegurar su proyección en el comercio exterior.
R iquelme sostuvo además que la iniciativa se enmarca en la política de fortalecimiento portuario impulsada por el Presidente Gabriel Boric, apuntando a un desarrollo integral de la infraestructura marítima nacional.
J unto con el impacto laboral, el proyecto contempla obras complementarias para la ciudad, como plazas, paseos y un nuevo ascensor, integrando la expansión portuaria con espacios de uso urbano.

Jueves 26 de junio de 2025

Las altas temperaturas de las últimas semanas han provocado una fuerte evaporación en las reservas de agua. En la imagen se aprecia cómo el nivel ha retrocedido, dejando ver sectores del fondo y una transparencia del agua que en otros momentos del año no suele observarse.
Antonia Orellana Guarello Ministra de la Mujer y Equidad de Género

Al asumir el 2022 la agenda de derechos sexuales y reproductivos llevaba años sin avances sustantivos, desde la aprobación de las tres causales. No porque su necesidad hubiera desaparecido, sino porque no eran prioridad, pese a las emergencias por fallas de pastillas anticonceptivas durante la pandemia y el continuo descenso de la tasa de natalidad.
En 2022, luego de un proceso fallido de mediación con las mujeres afectadas por las fallas de pastillas anticonceptivas en el gobierno anterior, trabajamos técnicamente con el Instituto de Salud Pública para que, ante eventuales fallas, se informe activamente, se permita su retiro del mercado en un máximo de 5 días, y les otorgamos un fondo para reforzar el programa de vigilancia y control de anticonceptivos.
Al asumir, a cinco años de la anhelada aprobación de la Ley de aborto en tres causales, la norma sobre objeción de conciencia limitaba el ejercicio de un derecho establecido por ley.
Y es que había zonas completas del país donde no se podía acceder a esta prestación por la alta concentración de médicos objetores, obligando a que mujeres y niñas tuvieran que viajar kilómetros para ejercer un derecho que ya les pertenecía.
Gracias a que como gobierno priorizamos modificar el reglamento que regula las tres causales, hoy las mujeres pueden conocer de antemano si quien las atiende es objetor de conciencia.
Además, la red de salud tiene la obligación de contar con personal disponible para estos casos y de mantener la información sobre la ley en un lugar visible, asegurando que ninguna mujer o niña quede sin la posibilidad de ejercer lo que la normativa garantiza. A eso se suma una norma técnica que busca orientar de forma práctica a los equipos que no recibieron indicaciones por años.
Asegurado ese piso mínimo estuvimos en condiciones de dar el siguiente paso: ingresar al Congreso el proyecto de aborto legal dentro del plazo de 14 semanas, que hoy se encuentra en la Comisión de Salud de la Cámara de Diputadas y Diputados. Hay quienes preguntan por qué no se presentó antes, y otros que señalan que no debe discutirse. Sin embargo, luego de escuchar a expertas, organizaciones y distintos gremios, identificamos que era imprescindible asegurar primero el cumplimiento de la ley vigente, en este caso, las tres causales para luego abrir un debate más amplio.
A diferencia de otros debates sobre objeción de conciencia este no debió pasar el test constitucional: la minoría que está en contra de las tres causales asumió que Chile hoy aprueba mayoritariamente esta norma y no desea retroceder en ella, como quedó claro el 17 de diciembre del 2023.
Nos vamos del Gobierno con la certeza de haber dado un primer paso firme que esperamos no tenga retrocesos. Falta mucho camino por recorrer, sí. El éxito de la medida de incorporación del examen de hormona antimulleriana en FONASA muestra la gran demanda por planificación familiar efectiva, por ejemplo.
Avanzar en democracia implica, en primer término, no aceptar vetos. Nuestra prioridad y convicción se cumplió: avanzar y no retroceder.
“Esta lamentable actitud que hemos visto empañó una instancia que pretendía ser republicana para conversar materias profundamente importantes para el país. El Presidente electo le puso como condición al Presidente en ejercicio retractarse de lo que él mismo después reconoce que era verdad. El presidente no se puede retractar de la verdad, él ha sido fiel a la verdad, está apegado a la verdad. (Boric) se intentó comunicar con Kast dada la gravedad de las sanciones que estábamos recibiendo por parte del gobierno de Estados Unidos”.
Camila Vallejo Ministra vocera de Gobierno T13.cl, 3 de marzo de 2026
EMPRESA PERIODÍSTICA EL OBSERVADOR
“La Verdad más que un valor es una actitud ante la vida”
Roberto Silva Bijit
Fundador y Presidente del Directorio:
Roberto Silva Bijit
Director:
Roberto Silva Binvignat
Jefe de Informaciones:
Gabriel Abarca Armijo
La Concepción 277 - Quillota www.observador.cl
Coordinadora Comercial:
Verónica Tapia Herrera ventasquillota@observador.cl
Fono: +56 9 8887 9747 - Casa Matriz - Quillota

Cuando pagar impuestos no es el problema, sino no entenderlos
Señor director:
Una de las mayores falencias del sistema tributario chileno no es su nivel de carga, sino su complejidad. Para muchos contribuyentes, cumplir se vuelve difícil no por falta de voluntad, sino por falta de comprensión.
Formularios, regímenes, declaraciones juradas, rectificaciones, fiscalizaciones electrónicas: el lenguaje técnico domina un sistema que impacta directamente en la vida cotidiana de personas y empresas. En ese contexto, errores simples se transforman en problemas estructurales.
Lo preocupante es que el desconocimiento no distingue tamaño. Pequeños emprendedores, profesionales independientes y empresas medianas cometen errores similares, muchas veces confiando en soluciones parciales o en asesorías que solo miran el corto plazo.
Un sistema complejo exige educación tributaria real y acompañamiento profesional permanente. No basta con declarar; hay que entender qué se está declarando y por qué.
Pagar impuestos sin entenderlos es cumplir a medias. Y en materia tributaria, cumplir a medias suele salir caro.
Carla Huerta Abogada Tributaria
“Basta de este tipo de cosas”
José Miguel Insulza, senador
“Si vamos a pasar cuatro años peleando vamos a arruinar este país. Basta de este tipo de cosas. Ni siquiera me voy a referir a quién crea los problemas (…) A mí no me importa quién tiene la culpa, quiero que tengamos una transmisión de mando como corresponde”.
(T13.cl, 3 de marzo de 2026)
Invitamos a nuestros lectores

“Chile pide consensos”
Fernando Chomalí, cardenal
“Como Chile tiene vocación de entendimiento y no de enfrentamiento, llamo a Gabriel Boric y a José Antonio Kast a que vuelvan a dialogar. Chile pide consensos y unidad. Además, sería un gran ejemplo para los jóvenes. El todo es más que las partes. ¡Atrévanse por amor a Chile!”.
(T13.cl, 3 de marzo de 2026)
Hinchas caleranos esperan con nerviosismo la sentencia sobre el caso de supuestamente haber infringido las bases del campeonato y las demandas de Everton y Cobresal
Ayer por la tarde el Tribunal de Disciplina de la ANFP sesionó como es habitual. Una sesión a la que estaban atentos los hinchas de Unión La Calera, preocupados por la posible resta de puntos por las denuncias de Everton y Cobresal, por el ingreso de Axel Encinas en ambos partidos, sumando seis extranjeros en cancha, y que amenazan con la pérdida de 6 unidades.
Pero una vez más, como ha sucedido en las últimas semanas, ayer no hubo sentencia respecto al caso de Unión La Calera. No es que se esperara que lo hubiera, ya que la dirigencia calerana sabía que era imposible que el Tribunal diera ayer un fallo.
Lo anterior debido a que para ayer y para este viernes se esperaban últimas diligencias, testimonios solicitados por la Primera Sala del Tribunal Autónomo de Disciplina de la ANFP y alegatos de clausura por parte de los abogados de ambas partes, por lo que cualquier posible sentencia queda postergada para quizás la próxima sesión.
Es muy probable que ya con la mayoría de los antecedentes en su poder, los miembros de la Pri-

mera Sala, redacten y entreguen una sentencia el próximo martes o dentro de la semana que viene.
Eso sí, independiente del tenor del fallo, favorable para Unión La Calera o favorable para Everton y Cobresal, seguramente habrá apelación y el caso pasará a ser analizado por la Segunda Sala del Tribunal de Disciplina.
Desde Unión La Calera ya anunciaron que acudirán hasta el TAS si los fallos son negativos para ellos, junto con dejar establecidos sus cuestionamientos al proceso que ha llevado adelante el Tribunal de Disciplina.
El presidente de Unión La Calera, Sebastián Pini, a la vez uno de los accionistas mayoritarios y de profesión abogado, hizo ver su molestia por una serie de situaciones que, según él, “ensuciaron” el proceso que revisa el caso.
Según The Clinic, el abogado argentino solicitó la nulidad del procedimiento debido a que los demandantes (Everton y
Cobresal) tuvieron acceso a un escrito de reposición entregado por Unión La Calera, antes que fueran notificados de manera formal por el Tribunal.
Además, Sebastián Pini acusaque el correo que se envía a ambos clubes, iba con copia a Exequiel Segall, presidente del Tribunal de Disciplina, quien se inhabilitó en este caso por su reconocido fanatismo por Everton y por ser ex dirigente del club viñamarino, quien “supuestamente, se inhabilitó por su cercanía con uno de los denunciantes pero estaría conociendo en este procedimiento, lo cual es inadmisible. Ese mismo denunciante, no copia al Tribunal”, señala el presidente de Unión La Calera.
En el mismo mail, Pini plantea la posibilidad de recurrir hasta el TAS si las eventuales resoluciones fueran negativos para Unión La Calera, repitiendo lo que sucedió hace dos temporadas cuando recuperó el punto que el mismo Tribunal le había quitado, tras empatar 2-2 con Audax Italiano.

Kimberley Ahumada sumó puntos clave que le pueden permitir volver a representar a Chile en competencias internacionales esta temporada
E l fin de semana, en las canchas del Club El Bosque de Viña del Mar, se disputó el Quinto Torneo Selectivo de Categoría Primera Damas, organizado por la Federación
de Pádel de Chile (Fepachi). La destacada jugadora quillotana Kimberley Ahumada, del sector de La Palma, hizo dupla con la número 1 del ranking nacional, Catalina Arancibia, y realizó una campaña impecable que les permitió coronarse campeonas.
E n la fase de grupos, el dúo venció por 2-0 a Amanda Vásquez y Antonia Salazar (6-0, 6-1), y luego superó por 2-0 a Aurora Candia y Macarena Lobos (6-1, 6-2). En semifinales, derrotaron a Trinidad Del Real y Amalia Bentjerodt por 2-0 (6-1, 6-4).
Ya en la final, Ahumada y Arancibia se impusieron por 2-0 a Noelia Suárez y Pamela Sannazzaro (6-4, 6-1), ratificando su superioridad en el certamen viñamarino y sumando puntos valiosos para el ranking nacional.
E ste triunfo consolida el buen nivel de la deportista quillotana, quien durante 2026 tendrá nuevas oportunidades para brillar en torneos nacionales y, potencialmente, volver a representar a Chile en competencias internacionales, como ha ocurrido en temporadas anteriores.
La actriz ingresó queja al CNTV y seguirá adelante con sus acciones penales y administrativas.
Yamila Reyna anunció la noche de este lunes que ingresó una denuncia en el Consejo Nacional de Televisión (CNTV) contra Primer Plano, estelar que conduce Julio César Rodríguez.
La actriz, además, recordó que ya entabló acciones legales para perseguir las responsabilidades penales o administrativas del programa de Chilevisión.
Según Yamila Reyna, el espacio de farándula incurrió en una “violación grave a mi privacidad, y constituye una revictimización evidente”.
“UNA VIOLACIÓN
GRAVE A MI PRIVACIDAD”: YAMILA REYNA SE DESCARGA
A través de una publicación en Instagram, Yamila Reyna publicó una captura de la denuncia en el CNTV y describió que busca tras el hecho.
“Ingresé denuncia en el Consejo Nacional de Televisión por la emisión del día domingo 15 de febrero de 2026 en el programa PRIMER
PLANO de CHILEVISIÓN
-hoy ya en tramitación-, a propósito del reportaje “¡Detalles inéditos del quiebre de Yamila y Américo!” en el que se exhibió el texto completo de la denuncia realizada en tribunales de familia”, partió explicando..
“Se trata de un documento reservado al cual SÓLO tienen accesos las partes. Sin perjuicio de las responsabilidades
penales o administrativas, las que también he solicitado directamente en tribunales, la exhibición constituye una violación grave a mi privacidad, y constituye una revictimización evidente”, agregó.
“No hay interés público alguno para justificar tal filtración y es una pésima señal para todas las víctimas de violencia intrafamiliar que deben confiar que el sistema judicial en su conjunto las debe proteger”, concluyó Yamila Reyna.


La productora avisó a través de la periodista que a la pareja de Emilia Dides tampoco lo invitarán más a fiesta Bresh.
Palabras sacaron palabras y desde la productora Bizarro sostuvieron que Sammis Reyes se encuentra vetado del Festival de Viña.
En el programa Zona de Estrellas se comunicaron con fuentes de la productora que organiza el certamen en la Quinta Vergara, luego de las quejas del ex jugador de la NFL.
“La gente de Bizarro me ha tratado mal, me trataron mal hoy. Siempre me trata mal, de forma despectiva. A ellos se les olvida que la gente que viene a ver este show son los protagonistas”, se quejó Sammis Reyes, lo que generó la respuesta de Bizarro.
“A ÉL LE GUSTA EL TRATAMIENTO VIP Y QUE LO TRATEN COMO UN REY”
Luego que la periodista Paula Escobar se contactó con Bizarro en Zona de Estrellas leyeron el comunicado demoledor en contra de la pareja de Emilia Dides.
“Él fue vetado del Festival
de Viña desde que Emilia Dides fue jurado del Festival en su versión 2025″, partió leyendo la comunicadora.
“Porque el tipo agredió a una de nuestras productoras mujeres y a un productor nuestro, porque quería tratamiento VIP”, agregaron desde la productora
“Desde entonces, tomamos la decisión de no invitarlo nunca más a nada, por ser agresivo”, subrayaron por medio de dicho mensaje.
“Y por eso este año, aunque llamaron para rogarnos para entradas para ellos,
dijimos que no. Y el día que fue, entró como una persona normal y eso no le gustó. A él le gusta el tratamiento VIP y que lo traten como un rey”, lo repasaron.
Pero desde Bizarro no se quedaron ahí y también se refirieron a la última pelea de Sammis Reyes con Cuco Cerda.
“Molestaron tanto, que los invitamos a la fiesta Bresh, casi ya por cansancio. La Bresh nos corresponde. ¿Y qué pasó? Se puso a pelear con otra persona y tuvimos que expulsarlo. Ahora tampoco podrá entrar nunca más a la fiesta Bresh”, finalizaorn. Créditos: www.lahora.cl




Una nueva contribución al tratamiento del cáncer está desarrollando la PUCV, a través de la innovación en la aplicación de terapia fotodinámica. En el marco de un proyecto Fodecyt Regular, desarrollan moléculas que –al absorber luz del espectro visible– generen especies con valor terapéutico y aplicaciones en el combate a esta enfermedad.
Tamara Maldonado, académica del Instituto de Química y del Doctorado en Ciencias mención Química de la Universidad, dirige el proyecto que busca ir un paso más allá en las terapias que usan luz, logrando
Investigadora del Instituto de Química de la PUCV diseña moléculas capaces de liberar especies terapéuticas al recibir luz visible, abriendo paso a tratamientos más precisos y con menos efectos secundarios en el combate a esta enfermedad.
que –tras el estímulo lumínico adecuado– las moléculas liberen ciertas especies capaces de acceder de manera específica en la célula para combatir el tumor.
“La idea es que nuestros sistemas ingresen de forma selectiva en las mitocondrias de las células, porque las mitocondrias
son un buen target para desregularla, por así decirlo, y que comience el proceso de apoptosis o muerte celular programada. Es decir, buscamos que sean sumamente específicos además de biocompatibles”, explicó la académica.
La investigadora añadió que es fundamental probar estas nuevas moléculas en sistemas tumorales tridimensionales y no sólo en cultivos celulares monocapa, para poder estudiar la efectividad de los compuestos en un ambiente más realista, por lo que el estudio también incluye este tipo de experiencias.
Cuando ciertas moléculas absorben luz visible, generan especies que tienen valor terapéutico como el óxido nítrico o monóxido de carbono en pequeñas concentraciones, así como especies reactivas de oxígeno –oxígeno singlete, principalmente– que son utilizadas para tratamientos contra el cáncer.
“Diseñamos una molécula que tenga ciertas propiedades, pero lo que más nos interesa es que absorba en determinada región del espectro visible. Por ejemplo, que absorba luz verde, luz naranja o luz roja, y que –tras ese proceso– ocurra un cambio en ella que haga que se liberen estas especies que tienen valor terapéutico”, detalló Tamara Maldonado.
Se trata de avanzar en la búsqueda de tratamientos efectivos y con menos efectos adversos para los pacientes, por lo que la especificidad en la terapia fotolumínica apunta a eso. “Cuando hablamos de diseño racional es diseñar nuestra molécula para que se vaya específicamente a un lugar de la célula. Aumentamos su efectividad, hacemos que el sistema sea mucho más eficiente, las diseñamos para que sean biocompatibles o poco citotóxicas”, complementó Maldonado.

Chile desempeña un papel crucial en la producción y exportación de semillas, siendo el principal exportador del hemisferio sur. Su producción de contra estación –cultivos en la temporada contraria a la del hemisferio norte– ayuda a satisfacer la demanda global, a reducir la escasez y a acelerar el desarrollo de nuevas variedades vegetales.
Sólo en 2024, el total de exportaciones de semillas fue de casi USD$ 400 millones, lo cual representa 38 mil toneladas de este producto, entre hortalizas, maíz, canola, soya, flores y forrajeras. En el país se multiplican nuevas variedades que los genetistas elaboran en base a la demanda mundial, tarea que en
Investigadores de la PUCV trabajan en una herramienta de monitoreo basada en machine learning, para aumentar la precisión en la producción de semillas híbridas y fortalecer la posición del país como referente en calidad y sustentabilidad agrícola.
algunas especies es realizada en forma manual, por cientos de operadores que manipulan las flores para polinizar y hacer las hibridaciones necesarias. Un proceso minucioso que se logra con gran precisión pero que, sin embargo, no está exento de errores.
Ante este escenario, académicos de la Escuela de Ingeniería Eléctrica y de la Escuela de Agronomía de la Pontificia
Universidad Católica de Valparaíso (PUCV) participan en una investigación conjunta para diseñar y desarrollar un dispositivo portátil para el monitoreo y trazabilidad del proceso de producción de semillas agrícolas de alto valor.
Según explicó Daniel Yunge, académico de la Escuela de Ingeniería Eléctrica, del magíster en Ciencias de la Ingeniería
Viene de página anterior
mención Ingeniería Eléctrica de la PUCV y director del proyecto FONDEF IT en el que se enmarca esta investigación, la idea es que el aparato capture imágenes y efectúe el procesamiento en terreno, detectando errores de manipulación de las flores durante el proceso de hibridación, con la consecuente reducción de pérdidas en la calidad de la producción.
“Se trata de una solución tecnológica que, a través de machine learning, detecta patrones en una imagen –en este caso, imágenes de distintos momentos de las flores que son trabajadas manualmente mediante emasculación y polinización– para dar cuenta de errores en el proceso y poder corregir a tiempo. Estamos pensando en utilizar una aplicación de smatphone, ya que los teléfonos inteligentes cuentan con la tecnología necesaria y son de menor costo de implementación frente a un dispositivo fabricado especialmente para el monitoreo”, detalló Yunge.
Para ello, el proyecto contempla la participación de la empresa LEM System, que ofrece soluciones tecnológicas al agro, como sistemas de monitoreo de invernadero, de riego, y proveen de datos a los agricultores.
La académica de la Escuela de Agronomía y del magíster en Ciencias Agronómicas y Ambientales de la PUCV, y co-directora del proyecto, Patricia Peñaloza, comentó que la agricultura de las semillas en Chile se distingue por su calidad por lo que es preferida por industrias multinacionales para el proceso de hibridación y creación de nuevas variedades. Añadió que “si agregamos un componente

tecnológico en el control de calidad del trabajo que se efectúa manualmente, nuestro posicionamiento a nivel internacional puede ser aún mejor y este proyecto apunta precisamente a eso”.
Sobre los fallos que el sistema detectará, la investigadora manifestó que “la probabilidad
de error implícita en la flor tiene que ver con la genética, la dificultad en la manipulación y los procesos de hibridación. Hoy día los errores no son muy altos, pero sí cuestan mucho porque el mercado compra una variedad, la identidad genética de una semilla, y un mínimo fallo en el
Viene de página anterior proceso puede generar una variedad distinta a la que se busca. El problema con la manipulación de semillas no es un tema de volumen, sino de precisión”.
Este proyecto se desarrolla en la Región de Valparaíso, que concentra gran parte de la producción de semilla híbrida manual, con un alto porcentaje de personal femenino involucrado en el proceso. Una de las empresas vinculadas con esta investigación es Agrícola Las Garzas, quienes proveen el servicio de hibridación de semillas, desde el cultivo de las plantas hasta la contratación del personal necesario.
La sustentabilidad en el manejo y producción de alimentos es un tema que cada día cobra mayor realce e influye en las políticas públicas tanto a nivel nacional como internacional. En este sentido, para la investigadora y formuladora del proyecto de la Universidad de Concepción, Silvia Riquelme, “el trasfondo del manejo de las semillas es fundamental ya que estamos hablando de asegurar la alimentación para el futuro”.
“Se trata de una idea innovadora que está completamente alineada con lo que nacionalmente se busca en agricultura, con los requerimientos alimentarios a nivel global y con la necesidad de ir incorporando herramientas tecnológicas a la agroindustria. Tanto en Chile como a nivel internacional se busca la mejora continua, evitar errores, hacer una trazabilidad. Hoy en día el manejo de datos es fundamental para el éxito en cualquier empresa”, comple-
mentó Riquelme.
Finalmente, Daniel Yunge destacó que con este proyecto también esperan mejorar la productividad de quienes manipulan las flores para la obtención de semillas, así como su calidad de vida. “A nivel mundial, se
apuesta por ir automatizando los procesos para incrementar la productividad, pero la tecnología también ayuda a mejorar las condiciones laborales de las personas que trabajan en este rubro, facilitando los procesos que deben llevar a cabo”.




Dirección
ARIES
(21 de marzo al 20 de abril)
AMOR: Si creía que su etapa de soledad iba a ser más larga, se equivocó, alguien llegará a su vida con una clara intención de hacerle feliz. SALUD: No se estrese por todo, trate de mantener siempre la calma. DINERO: mejoran sus posibilidades. COLOR: Blanco. NUMERO: 19
TAURO
(21 de abril al 20 de mayo)
AMOR: Busque su yo personal, reflexione y se le aclararán las cosas. SALUD: No coma tanto de noche, no va a tener buenas horas de sueño. Incluso puede sufrir pesadillas. DINERO: Su esfuerzo será recompensado, no pierda la fe en lo que le espera. COLOR. Marrón. NUMERO: 22.
GEMINIS
(21 de mayo al 21 de junio)
AMOR: No se apresure, se puede equivocar. Espere un poco y sea paciente. SALUD: Cuide sus oídos, visite un médico. Necesita distraerse con deporte. DINERO: No sea dadivoso y cobre el valor que corresponde. No haga negocios con familiares. COLOR: Violeta. NUMERO: 15
CÁNCER
(22 de junio al 22 de julio)
AMOR: Superó el mal momento, pero ahora viene lo bueno y reconfortante. Trate de vivirlo intensamente. SALUD: Sus emociones se descontrolan por el exceso de trabajo. Evítelo mostrando más fortaleza. DINERO: Cuidado con los negocios. COLOR: Beige. NUMERO: 3



LEO
(23 de julio al 22 de agosto)
AMOR: Una persona cercana puede generar problemas en tu relación, abre los ojos. SALUD: Ten algo de cuidado con problemas respiratorios. DINERO: Tendrá algunos conflictos en el trabajo que enturbiarán el ambiente laboral. COLOR: Rojo. NUMERO: 21.
VIRGO
(23 de agosto al 22 de septiembre)
AMOR: Recuerde que después de la tormenta sale el sol. No te compliques tanto por los problemas con el sexo opuesto ya que es momentáneo. SALUD: Cuidado con los resfríos. DINERO: Será fuerte en momentos muy difíciles, pero necesitará a su familia. COLOR: Gris. NUMERO: 32.
LIBRA
(23 de septiembre al 22 de octubre)
AMOR: Tenga cuidado con sus arrebatos ya que no es bien visto por la persona que usted espera sea su pareja. SALUD: Coma frutas y verduras. Debe nutrirse mejor. DINERO: Busque una nueva herramienta de trabajo que aumentará su ingreso económico. COLOR: Verde. NUMERO: 27
ESCORPIÓN
(23 de octubre al 22 de noviembre)
AMOR: Después de una desilusión amorosa viene la recompensa, no pierda la esperanza. SALUD: Prefiera las hortalizas, antes que carnes y comidas rápidas. Cuide su aparato digestivo. DINERO: Aparecen dineros extras que ayudarán a sus problemas. COLOR: Anaranjado. NUMERO: 6
SAGITARIO
(23 de noviembre al 20 de diciembre)
AMOR: Encontrará la comprensión de las personas que lo/a estiman. Va a encontrar un buen amor más adelante. SALUD: Vaya desde ya organizando un descanso. DINERO: Aléjese de las tentaciones y procure economizar algo de su sueldo. No derroche. COLOR: Negro. NUMERO: 23.
CAPRICORNIO
(21 de diciembre al 20 de enero)
AMOR: Su dulzura seduce a toda persona. Haga uso de sus encantos. SALUD: Los alimentos procesados terminan por dañar el organismo, busca lo natural. DINERO: Se presenta una buena oportunidad. Su situación va a mejorar muy pronto. COLOR: Amarillo. NUMERO: 1
ACUARIO
(21 de enero al 19 de febrero)
AMOR: Piense en lo bello que le está pasando. No lo eche a perder con sus afanes aventureros que a nada lo llevan, salvo a perjudicar su relación. SALUD: Problemas en la espalda. DINERO: Tenga cuidado con los amigos de lo ajeno. No deje su hogar solo. COLOR: Granate. NUMERO: 13
PISCIS
(20 de febrero al 20 de marzo)
AMOR: Calme un poco su ímpetu, debe estar más tranquilo/a antes de tomar decisiones tan importantes. SALUD: Cuidado con los dolores de cabeza, visita a un médico. DINERO: Mejora su estabilidad laboral. Actúe con responsabilidad. COLOR: Lila. NUMERO: 10.
PROVINCIAS DE QUILLOTA Y PETORCA
SSANGYON KORANDO, año 2013, automático, diésel, $5.500.000 conversable, buen estado, documentos al día. Fono 995793289.
RENAULT DUSTER, 2022, único dueño, $ 9.490.000. KIA RÍO, hatch back, 2015, $5.450.000. MG3, hatch back, 2014, techo y llantas, $5.450.000. Toyota Yaris, sedán, 2000, hidráulico, $2.790.000. WhatsApp Fono +56 9-94998176 Cuneo Autos.
TOYOTA YARIS, 2008, sedán, único dueño, $3.850.000. Nissan Tiida, sedán, 2007, segundo dueño, $ 3.850.000.Citroën C1, 2008, diésel, $3.850.000. WhatsApp Fono +56 9-94998176 Cuneo Autos.
AUTOMOVIL HYUNDAI Sovata. 2001, 2.0 cc, neumáticos nuevos, llantas techo, eléctrico, full equipo. $2.150.000. Oportunidad. 985722579 CHERVROLET SPARK. GT 1.2 cl, 2012. Full equipo, neumáticos, bateria nueva, radio touch. 7”. 4 k. Impecable. $3.850.000. 985722579. CHEVROLET AVEO 2009 1.4 full equipo aire acondicionado airbag llantas papeles al dia 2.950.000 999224119
120 Camionetas y todo terreno venden
PROVINCIAS DE QUILLOTA Y PETORCA
NISSAN NAVARA, doble cabina, año 2008, diésel, mecánica, $6.000.000 conversable, documentos al día Fono 995793289.
NISSAN QASHQAI, 2015, $5.990.000. Nissan D-21, doble cabina, 2008, $3.990.000. Whatsapp Fono +56 9-94998176 Cuneo Autos.
130
Furgones, buses y camiones venden ordenados por marca
PROVINCIAS DE QUILLOTA Y PETORCA
SE VENDE Microbús Mercedes Benz, año 2004, con recorrido Comercial Guerra. Interesados 332 310366-990561519.
150 Taxis y otros vehículos venden.
PROVINCIAS DE QUILLOTA Y PETORCA
VENDE COLECTIVO Toyota
Yaris japonés, año 2014, joyita trabajando, papeles al día. Precio conversable. Contacto 974925494.
a la calle y otro interior, central, para una persona que trabaje, $260.000. Teléfono: 964258161. 979598791
SE ARRIENDA casa pleno centro de Quillota, Chacabuco con Freire, 4 dormitorios, 1 baño. con estacionamiento. $ 500.000.- mensuales. Llamar celular +56 9 9542 6779
SE ARRIENDA Casa habitación, tres dormitorios, cocina ampliada, bañó y patio. Andrea Verrochio 1149, Leonardo Davinci. Quillota. Desde el mes de marzo hasta disponible la casa, fono 988552695 $400.000 con mes de garantia. Solicita la persona con contrato de trabajo, se puede visitar desde las 18:00hrs en adelante.
SE ARRIENDA habitaciones para escort. Contacto +56976739661.
SE DA alojamiento mensual o permanente, amueblado, gasto comuniones incluidos. Solo una persona Valor $260.000. +56963493260
SE ARRIENDAN pieza a estudiantes, empresas o persona sola, buena ubicación, sector Acuenta de Diego Echeverría, mall centro y terminal de buses, valor $160.000, incluye gastos básicos. Llamar a +569 98638361.
ARRIENDO CASA interior, dos dormitorios, living, comedor y cocina, un baño. Excelente ubicación, sector tranquilo, locomoción cercana, supermercados, y colegios en el área, $300.000, incluye, luz, agua, cable y wifi. La Corvi, Quillota +569 46107448.
ARRIENDO CASA, casa condominio La Cruz $ 600.000 2D+2B Gastos comunes Incluídos. +56 973537582
DEPARTAMENTO
CONDOMINIO Alcalá, paradero 12. La Cruz, 3 dormitorios, 2 baños. estacionamiento, tercer piso. $425.000. Corredora +56967397644
HABITACIÓN SECTOR Residencial, pasos locomoción, Wifi, cable, derecho cocina, lavadora, Avenida 21 de mayo 1590, La Cruz, paradero 10. Ideal estudiantes, turistas, alojamiento diario, semanal, mensual, anual. +56967397644
QUILLOTA ARRIENDO, departamentos amoblados, 2 dormitorios, remodelado, central. $350.000, $400.000, garantía, comisión, mgpropiedades2023@gmail. com Contacto +56968087082.
ARRIENDO CASA amoblada a empresa. 4 dormitorios, 2 baños, estacionamiento y demás. Contacto 982654460 Quillota
ARRIENDO PIEZAS en Quillota. Sector Centro, para persona sola. Valor $230.000 con servicios incluidos: Luz, agua, gas y WiFi. Tratar con Sercon Propiedades al +56958075021.
HABITACIONES AMOBLADAS a empresas, baño privado, estacionamiento, persona sola, Internet, lavadora, secadora, cocina, +56982654460. Quillota.
HIJUELAS ROMERAL, casa para empresas, 5 dormitorios, 2 baños, terreno de 1.000 metros cuadrados $1.200.000 mensual. Propiedades Santa Irma fono 993696944.
LA CALERA, casa 2 dormitorios, Villa O’Higgins, $380.000 mensual. Propiedades Santa Irma fono 993696944.
220
EXCELENTE OPORTUNIDAD comercial en Quillota Arriendo propiedad con destino comercial, ubicación privilegiada a 3 cuadras de Plaza de Armas y pasos de Av. Condell. Gran flujo peatonal y
conectividad total. Superficie: 800 metros cuadrados de terreno y 190 metros cuadrados construidos. Cuenta con planta libre, 4 oficinas, 3 baños, cocina y amplia galería techada. Estacionamiento para 6 vehículos y gran patio Valor: UF 47. Contactar +56963441645.
VENDO PERMUTO casa central Quillota, 2 dormitorios, living comedor, baño, cocina, antejardín, entrada auto, 999265923.
VENDEN SUS dueños Casa La Calera sector residencial, Living, comedor, 4 dormitorios, 2 baños, cocina, piscina, estacionamiento. Celular +56996471182 +56994548547 +56998206041.
CASA SECTOR Residencial, Avenida 21 de mayo 1590, La Cruz, Conjunto La Foresta, panel solar, a 250mts. Quillota, supermercado, pasos locomoción, 6 habitaciones, 4 baños, estacionamiento, excelente rentabilidad. $1.140.000 mensual. Valor $144.000.000. Vende dueña +56967397644
LINDA CASA, paradero 10, Avenida 21 de mayo, La Cruz, cerca supermercado, pasos locomoción, Conjunto La Foresta, panel solar, 3 dormitorios, 2 baños, cocina, estacionamiento, 2 vehículos. $95.000.000 conversable. Corredora +56967397644
VENDO CASA 2 pisos, 2 baños, Benimeli, Quillota. $82.000.000. Contacto 934364962, dueño.
VENDO DEPATAMENTO KPD en Belloto Sur. 2 dormitorios, living/comedor, pequeño balcón. A pasos de carabineros consultorio. Impecable, ventanas termo paneles. 940173407 984056572
Casas y departamentos. 235
QUILLOTA VENDO casa Yungay, 4 dormitorios, dos baños, entrada auto, pleno centro 991630769.
QUILLOTA, VENDO departamento pleno centro, dos dormitorios, dos baños, amplio, precio conversable. Contacto 991630769.
VENDO 5.000 m2, factibilidad luz, agua, sector tranquilo, seguro, documentación en regla, La Peña de Nogales. Fono 989768011.
VENDO PARCELAS Planas 5.000 m2., El Olivo, Nogales. Sector tranquilo a orilla de camino. Consultas +56 9 93077456.
EL MELON terreno1.04 hectáreas al final de la población Juanita Fernández, terminal Limequi. Interesados llamar 951852030.
SE VENDE Parcela 7,21 hectáreas en la comuna de Zapallar sector El Pangue, cerca de playas Zapallar y Chachagua, $115.000.000 conversable. Fono 968498183.
VENDO TERRENO 5.000 metros cuadrados, al lado del nuevo Patio Outlet La Calera Ubicación estratégica comercial contigua a Outlet. Ideal Mall Chino, estacionamientos o inmobiliario. Cuenta con factibilidad de agua potable, luz trifásica y camino asfaltado. Oportunidad de inversión inmediata. Fono: +569 63441645.
TERRENO URBANIZADO Calle
Oscar Bonilla, cerca Avenida Valparaíso, Quillota, 210m2. $38.000.000. Corredora. +56967397644
QUILLOTA, VENDO terreno 500 m2., semi urbanizado, sector calles Alemania, Freire. 991630769.
TERRENO 4.000 m2., sector
Quebrada Ají, Quillota, precio conversable. Contacto 991630769.
AGRÍCOLAS Y FORESTALES
PROVINCIAS DE QUILLOTA Y PETORCA
VENDO ALCAYOTAS por unidad o por kilo y plantas mantos de Eva. F:976539839 La Calera. VENDO 1.35 acciones de agua del Canal Purutún, Hijuelas. Interesados llamar 991802105.
PROVINCIAS DE QUILLOTA Y PETORCA
HAMACA COLUMPIO con pedestal $40.000 con cojines incluidos. Bicicleta “Masterfit” para hacer ejercicios $45.000. Linda mesa de centro, madera noble con vidrio $70.000. +56967397644.
PROVINCIAS DE QUILLOTA Y PETORCA
CONSTRUCCIÓN
DOMICILIARIA techumbres, carpintería, albañilería, radier, estucos, cerámicos, pintura interior, exterior, demoliciones. Presupuesto 985840185
GASFITERÍA SERVICIO integral: instalación, mantención artefactos sanitarios, cálefont, alcantarillado. Presupuestos 921987478.
SERVICIOS EN GENERAL 550
PROVINCIAS DE QUILLOTA Y PETORCA
AMARANTA TAROT, ven a descubrir que depara tu destino. Martes y viernes de 11:00 a 20:30 horas, horario continuado. Freire, 1025. 995400565.
TASACIONES MINVU y particulares, toda la Región Valparaíso. Agilidad entrega informes. Peritos tasadores +56967397644
DIVORCIO. FACILIDADES de pago. Quillota-Abogados. Fono +56 991264805, Email: camila.maldo.c@gmail.com

PROVINCIAS DE QUILLOTA Y PETORCA
610
BUSCAMOS CONDUCTOR part time traslado de carga pesada y productos entre Quillota, Santiago y ciudades intermedias. Licencia clase B vigente, experiencia en conducción de carga y documentación al día. Persona responsable y puntual, idealmente residente en Quillota. enviar cv a constanza@ cerveceraaltamira.cl
BUSCAMOS DISEÑADOR grafico Full-time para diseño y gestión de redes sociales. Con experiencia comprobable. Encargado de crear contenido, tomar fotografías para desarrollar piezas graficas, responder mensajes internos, analizar métricas y todo lo relacionado a gestiones de diseño y redes. Proactivo y que resida en Quillota o alrededores.Enviar CV y portafolio al correo constanza@ cerveceraaltamira.cl
ESCUELA CATÓLICA ubicada en Catemu, requiere contratar para el año 2026, a los siguientes profesionales Profesor Lenguaje 44 horas, Profesor de Matemáticas 17 horas, Profesor de Educación Tecnológica 14 horas, Educador
Diferencial 44 horas, Profesor de ciencias 12 horas, Inspector de patio 44 horas, Coordinador de apoyo (docente orientador por 44 horas). Los curriculum deben ser enviados al correo: rector@salesianoscatemu.cl
NECESITO ASESORA del hogar puertas adentro, lunes a sábado, cuidar adulto mayor autovalente, para nogales. Fonos 965964322, 986120164.
RESERVA ECOLOGICA Oasis La Campana, Hijuelas, requiere guardia de seguridad con curso OS-10 al día, manejo computacional y movilización propia. Enviar certificado antecedentes, certificado curso OS-10 y currículum vitae, al correo administracionreoc@ reserva.cl
SE NECESITA Electromecánico automotriz, (que realmente ejecute el trabajo de electromecánico) y Mecánico, con ganas de trabajar, proactivo, amigo de las herramientas, no del celular. Dejar currículum en Josefina 614, La Calera, fono WhatsApp +56949674436.
SE NECESITA personal para privado. Contacto +56976739661.
SE NECESITA personal para privado. Contacto +56976739661.
SOPORTES ELÉCTRICOS. Empresa del rubro prestación de servicios eléctricos en terreno, necesita SOPORTE ELÉCTRICO. Postulantes con títulos y experiencia a fin. Varones, con licencia vigente de conducir clase B. Interesados enviar CV, títulos, referencias laborales y pretensiones de sueldo al correo junior.rrhh@ eurogestion.cl
TERMINAL DE Buses La Calera, requiere dama para área administrativa con conocimiento en computación. Interesadas contactarse al 941979530.
PROVINCIAS DE QUILLOTA Y PETORCA
Empleos ofrecen 610
BUSCAMOS: TÉCNICO
Químico, Químico Analista, Bioquímico, Químico Industrial o carrera afín, con experiencia mínima de 1 año y que viva en la provincia de Quillota. Interesados enviar C.V. a evs@ vicaconsultores.cl, indicando pretensiones de renta y disponibilidad.
EMPRESA CONSTRUCTORA
De la zona necesita contratar arquitecto con experiencia en tramites municipales. Quillota
o alrededores. constructoraarevalo8@gmail.com
SE BUSCA vendedor/arepartidor/a de Confites y Helados para la zona de La Ligua-Cabildo-Petorca. Perfil: Experiencia comprobable en reparto y ventas en ruta. Residencia cercana a la zona. Responsable y con orientación a cumplir metas. Vehículo propio, Licencia de conducir al día. A prueba de 1 a 3 meses con contrato, renovación según desempeño. Educación mínima: 4º medio. Enviar antecedentes a: ventascongeladoshorcon@ gmail.com
RESTAURANTE CHINO, ubicado en 21 de mayo Nº 4015, La Cruz (paradero 15). Necesita garzón o garzona, buena presencia. 978115039.

SE NECESITA joven con experiencia para trabajar en minimarket, turno tarde. llamar al +56942832454. Solo interesados
AYUDANTES MAQUINARIAS. Se necesita contratar Ayudantes de Maquinarias. Trabajo estable. Ideal egresado de liceo industrial. De lunes a viernes y sábado mediodía. No se requiere experiencia previa. Residencia en la comuna de Quillota o alrededores. Enviar currículum a maderasqta@ gmail.com
LICEO TÉCNICO Agrícola requiere Jefa de UTP, Educadora Diferencial, docente de Lenguaje y docente de música. Enviar antecedentes a docenteslacruz@rcristo.cl
Empleos buscan 620
PROVINCIAS DE QUILLOTA Y PETORCA
SE OFRECE asesor de hogar, puertas afuera, para aseo. (9)84370775 Quillota SE OFRECE señora para cuidado de adulto mayor o que haceres de casa, disponibilidad inmediata, recomendaciones. Fono 977517481.
SEÑORA JACQUELINE ex mucama le deja su casa impecable, disponibilidad inmediata. Quillota. Contacto 956762664 .
SE OFRECE trabajador con licencia de conducir, ideal para parcela ojala con casa, además experiencia en construcción, planta de áridos. Llamar 950471686.
Continúa en página siguiente

Viene de página anterior
700
OTROS AVISOS
PROVINCIAS DE QUILLOTA Y PETORCA
ELEAM MARGARITA Escobar
Casa de Familia ofrece cuidado al Adulto Mayor, las 24 hrs con atención personalizada en un grato ambiente familiar en Limache llamar a 986302056 Margarita Escobar.
SE VENDE en Parque Rauquén sepultura, tres capacidades y reducción. Llamar a +56938893594
SE VENDE patente de alcoholes en La Calera, clase A. Llamar +56936596633.
CONTACTOS PERSONALES 720
PROVINCIAS DE QUILLOTA Y PETORCA
AGENCIA NECESITA chicas, +56976739661.
ANDREA CHILENA, servicio completo, buen trato, lugar propio, $20.000 el contacto. +56953917745.
NUEVA COLOMBIANA, madura, rica, complaciente, trato de novia. Contacto 933212517.
SANDRA MASAJISTA, a todo servicio, +56953917745.
NORMAL
$17.00 0.00 0.
VE NDO TERRENOS planos 300m2, en Pachacamita, con factibilidad de luz y agua. Fono 123456789. $17.00 0.00 0.
VE NDO TE RRENOS planos 300m2, en Pachacamita, con factibilidad de luz y agua. Fono 123456789. $17.000.000.
Tipografía normal con las 2 primeras palabras destacadas en mayúscula y letras en negrita.
Tipo de económico normal pero con dos barras de dos milímetros de grosor en la parte superior e inferior del anuncio.
Tipo de económico Remarcado pero todas las letras van en negrita.
QUILLOTA
La Concepción 277
Fono: (33) 2342210
CASA CUATRO dormitorios, cocina, dos baños, showerdoor, antejardín, patio techado. cerámica, $15.000.000. F: 123456789, La Cruz
Aviso con letras blancas sobre fondo rojo o negro.
ECONÓMICO VIÑETA
Aviso dentro de un globito tipo historietas con fondo amarillo y letras negras.
LA CALERA
Arturo Prat 797
Fono: (33) 2342216
oficinaquillota2@observador.cl

LEGALES Y PÚBLICOS 750
EXTRACTO. JUZGADO de Letras de La Letras, causa ROL C-1672-2024, caratulada “LILLO/SALINAS”, por fallo de fecha 06 de marzo de 2025, se declara interdicción provisoria por demencia de AMELIA ROSA SALINAS CORTES , C.I 7.096.832-0, quedando privada provisoriamente de la administración de sus bienes. Jefe de Unidad de Causas.
REMATE: ANTE 3º JUZGADO CIVIL VALPARAÍSO, Prat 779, 6º piso, Valparaíso, causa “FISCO DE CHILE con MUÑOZ”, Rol C-2842-2024, Juicio Ejecutivo, el día 19 de marzo de 2026 a las 11:00 horas, mediante video conferencia, se rematará el Departamento Nº104 y el uso y goce exclusivo del Estacionamiento 66, ambos del Condominio Don Benjamín, ubicado en calle Vicuña Mackenna Nº240, Comuna de Quillota, que se encuentran singularizados en los planos agregados con el Nº543, el estacionamiento, y bajo el Nº546, el departamento, ambos del Registro de Documentos del año 2020 del Conservador de Bienes Raíces de Quillota. La propiedad se encuentra inscrita a fojas 1.233, Nº507 del Registro de Propiedad del año 2023, del Conservador de Bienes Raíces Quillota. Mínimo para la subasta: $38.083.261.Todo postor para participar en
la subasta deberá tener activa su Clave única del Estado y rendir caución suficiente (10% del mínimo), mediante consignación en la cuenta corriente del Tribunal mediante cupón de pago, en la cuenta corriente del tribunal, o vale vista a la orden del juzgado, el que deberá ser entregado físicamente en la Secretaría, con a lo menos 48 horas de anticipación a la audiencia de remate. No se admitirán transferencias electrónicas u otras formas de pago que no sean las indicadas. Postores interesados deberán ingresar comprobante legible de rendición de la caución a través del módulo de remates especialmente establecido al efecto en la Oficina Judicial Virtual, con a lo menos 4 días hábiles de antelación a la fecha fijada para remate, indicando además la individualización del postor, si participará para sí o para un tercero, indicando el rol de la causa, correo electrónico y un número telefónico de contacto. Será de cargo de los comparecientes, contar con un dispositivo, computador, teléfono, Tablet u otro, con cámara, micrófono, audio y conexión a internet. Mayores antecedentes disponibles en la causa. Secretaria.
CÍTESE A los miembros de la Corporación Misión Refugio Esperanza a su reunión ordinaria a realizarse el sábado 07 de marzo del 2025, en calle a Av. Alejandro Escobillana Nº 956, Villa Los Torunos, comuna
de Graneros, VI Región, a las 09:30 en Primera Convocatoria, y a las 10:00 hrs en Segunda Convocatoria
CUERPO DE Bomberos La Cruz. Cita a los voluntarios a eleccio -
nes de Oficiales Generales para el domingo 08/03/26, desde las 10:00 horas hasta las 15:00 horas. Lugar cuartel avenida 21 de mayo 5200, La Cruz.
PROFUNDAS A MALL CHINOS EMPADRONADOS DURANTE 2025, CURSANDO 229 CLAUSURAS Y 332 INFRACCIONES
Uno de los focos prioritarios del trabajo desplegado en terreno por el SII durante este año, apunta a los denominados “Mall Chinos”, un tipo de comercio al por menor, que vende muchos productos, muy diversos, a precios muy bajos, que se masificaron en los últimos años, y para los que no existe un código de actividad económica especifica, lo que dificulta su identificación.
En este contexto, además de los procesos habituales de fiscalización en terreno, el Servicio desarrolló este año, además de su plan regular de controles en terreno, 2 operativos masivos especiales en todo el país, destinados específicamente a este tipo de comercio, en abril y junio.
La Directora (S) del SII, explicó que “culminado el proceso de empadronamiento y caracterización que realizamos a través de estos operativos, pudimos seleccionar para fiscalizaciones en profundidad aquellos casos que registran los mayores riesgos de incumplimiento tributario. Así, ya comenzamos la aplicación de diversos análisis y procesos de fiscalización más profundos a más del 80% de los 1.188 mall chinos empadronados a septiembre de este año, lo que confirma la relevancia de controlar a este tipo de establecimientos”.
Incumplimientos detectados
Desde enero a la primera semana de diciembre, el Servicio de Impuestos Internos realizó 2.747 acciones de fiscalización en terreno a Mall Chinos, en los que se controló la emisión de boletas o vouchers, además de aplicar puntos fijos y acciones de empadronamiento. En estas actividades en terreno se cursaron 332 infracciones por la no emisión de estos documentos tributarios, aplicándose además 229 clausuras temporales a este tipo de establecimientos. En el mismo periodo, se cursaron multas por más de $63.000.000.
“Lo que buscamos es lograr el correcto cumplimiento tributario de estos contribuyentes, y a la vez generar un efecto ejemplarizador en otros comercios de similares características, especialmente considerando la masividad de este tipo de comercios en los últimos años, traspasarle la importancia de cumplir con el pago de los impuestos y trabajar en igualdad de condiciones con todos los comercios”, subrayó Carolina Saravia.
En paralelo, la institución está incorporando la información obtenida a los modelos de análisis de riesgos del Servicio, para integrarla de manera permanente a los planes de fiscalización orientados al sector comercio.
Puntos Fijos
Como parte de las acciones de cumplimiento tributario en terreno, el SII aplicó el mecanismo de punto fijo en los mall chinos, es decir, controles en los que un equipo de fiscalizadores permanece en el establecimiento por un tiempo determinado, con el objetivo de verificar in situ el comportamiento tributario del contribuyente (principalmente en lo que a emisión de boletas se refiere), contrastándolo con su actividad habitual, cuando los funcionarios del SII no están presentes.
Este mecanismo permitió verificar que los comercios controlados mediante un punto fijo aumentaron la emisión de documentos tributarios el día de dicho control, nivel que mantuvo los 5 días siguientes. Sin embargo, desde el sexto día de la aplicación del punto fijo, comenzó a registrar una disminución sostenida en la emisión de documentos tributarios, llegando a niveles similares a los registrados antes de la aplicación de la fiscalización con punto fijo.
Frente a estos datos, la Directora (S) del SII afirmó que “lamentablemente, hemos podido constatar que los mall chinos representan un tipo de comercio que requiere de la aplicación de acciones permanentes de control, para asegurar su cumplimiento tributario. Sin esas acciones, tienden a reducir la emisión de documentos tributarios, aumentando su riesgo de no pago correcto de IVA. Es por ello que mantendremos nuestras acciones en terreno dirigidas a este segmento”.

Viene de página anterior LEGALES Y PÚBLICOS 750
CORPORACIÓN DE desarrollo comunidad Las Palmas cita a Asamblea Extraordinaria, el sábado 7 de marzo de 2026, en primera citación 17:30 horas, en su Casino, sector los Corrales s/n, Las Palmas. Tabla: 1. Autorización de aporte a campaña solidaria.
CORPORACIÓN DE desarrollo comunidad Las Palmas cita a Asamblea Extraordinaria el sábado 7 de marzo de 2026, en segunda citación de 18:00 a 19:00 horas, en su Casino, sector los Corrales s/n, Las Palmas. Tabla: 1. Autorización de aporte a campaña solidaria.
EXTRACTO SOLICITUD DE RENOVACIÓN DE CONCESIÓN MARÍTIMA MAYOR. CLUB DE YATES PAPUDO, RUT Nº 71.383.900-0, ha presentado ante la Subsecretaría para las Fuerzas Armadas, mediante su plataforma digital disponible para el efecto una solicitud de renovación de concesión marítima Mayor, número de trámite Nº CM61004, sobre un sector de TERRENO DE PLAYA, PORCIÓN DE AGUA Y USO DE MEJORA FISCAL en el lugar denominado Bahía Papudo, comuna de Papudo, provincia de Petorca, Región de Valparaíso. A modo referencial se señala(n) la(s) siguiente(s) coordenada(s) geográfica(s):
Latitud 32º30’13,01” S, Longitud 71º27’02,58” W. El objeto de la solicitud consiste en “continuar usufructuando las mejoras fiscales existentes, correspondientes a muro de contención, terraza de hormigón, dos piscinas y dos grúas de carga; y amparar la instalación de un atracadero flotante, una chaza, y 86 boyas de amarre para embarcaciones menores de 25 TRG”. Los antecedentes de la solicitud se encuentran a disposición del público en la plataforma de tramitación digital disponible en https:// portalconcesiones.ssffaa.cl, los cuales también podrán ser visualizados en la Capitanía de Puerto respectiva.
SEÑOR(A) ACCIONISTA: La comunidad de Aguas Canal Rautén , cita a una Asamblea General Ordinaria de Accionistas a efectuarse el día 14 de marzo 2026, en la Sede Comunitaria de Rautén, en primera citación 10:30 horas y en segunda citación 11:00 horas. -Cuenta 2025. - Avance inscripción derechos de aguas en la CPA. -Presupuesto 2026.Fijación cuota 2026. -Participación concurso CNR Nº05-2026. -Elección directorio. – Varios.
CITACIÓN: LA Cooperativa de Servicio de Agua Potable De Americana Ltda. Cita a sus socios(as) a Asamblea General, para el día Domingo 15 de marzo de 2026, a las 11:00 horas en primera citación y 11:30 horas en segunda citación. Lugar Sede Cooperativa
ubicada en Pasaje Mena Nº55 Petorquita, Hijuelas. Tabla: Palabras de bienvenida. Lectura Acta Anterior. Estado Contable (balance 2025). Varios. NOTA: La NO asistencia a reunión tendrá una multa de $5.000.
CONSEJO ADMINISTRATIVO.
EXTRACTO TRIBUNAL FAMILIA VILLA ALEMANA, Causa RIT C-892-2024, “TORRES/ALMARZA”. Divorcio por culpa. Resolución 23 ENERO 2026: OBJETO DEL JUICIO: procedencia de la declaración del término del matrimonio por divorcio por causal culposa. HECHOS A PROBAR: 1. Existencia del vínculo Matrimonial entre las partes. 2. Existencia de falta imputable al cónyuge demandado. 3. Efectividad que dicha falta constituya una violación grave de los deberes y obligaciones que impone el matrimonio a los cónyuges o para los hijos tornando con ello intolerable la vida en común. 4. Efectividad que el demandado ha incurrido en la causal del artículo 54 Nº1 de Matrimonio Civil, es decir atentado contra la vida, malos tratos graves contra la integridad física o psíquica del cónyuge o hijos, como asimismo la considerada el artículo 54 Nº3 de la misma disposición, condena ejecutoriada por la comisión de crimen o simple delito contra el orden o la familia, contra la moralidad de la familia, moralidad pública o contra las personas que involucre una grave ruptura de la armonía conyugal. CITACIÓN A AUDIENCIA DE JUICIO: Se cita a las partes a audiencia para
el día 07 de mayo de 2026, a las 10:00 horas en Sala Nº2, entendiéndose citadas las partes bajo apercibimiento que la audiencia se celebrará con las que asistan, afectándole a aquella que no concurra todas las resoluciones que en ella se dicten, sin necesidad de ulterior notificación. Notifíquese al demandado don FABIÁN IGNACIO ALMARZA HIDROBO por aviso conforme lo dispuesto en el artículo 54 del CPC mediante una publicación en el diario de circulación local del auto de prueba, atendido a que se le está enviando a absolver posiciones. Dirigió la audiencia y resolvió SS. MARCELA VILLEGAS MARABOLI, Jueza (S) del Tribunal de Familia de Villa Alemana. CLAUDIA ROJAS VILLARROEL MINISTRO DE FE.
SE EXTRAVIARON 2 certificados de Escuela de Conductores Nº A2 766933 y A4 766934 a nombre de Francisco Ramos Gatica.
EXTRACTO: EN Causa Rol V-208-2025, caratulado “OPAZO” , del Juzgado de Letras de Villa Alemana, juicio sobre interdicción por demencia, por resolución de 20-022026 se cita a audiencia de parientes de doña Elizabeth Judith Ibaceta Arriagada, RUT: 13.227.886-5 , para el día 11 de marzo de 2026, a las 10:30 horas, vía remota link de conexión Join Zoom Meeting https:// zoom.us/j/98701698611 / Meeting ID: 98701698611
